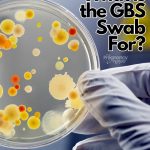
Pinterest Hidden Image

Are you pregnant? If so, you should know about GBS screening. GBS (group b Strep — also known as Beta Strep) is a bacteria that can cause problems for newborns, such as sepsis (a life-threatening infection). That’s why all pregnant women are screened for GBS at around 36 weeks gestation. Knowing if you have GBS helps your doctor decide how to care for your baby after he or she is born. Learn more about GBS and the benefits of getting screened in this blog post.

Before we get started, I also have a video on this topic:
What is group B strep?
It is from the family of Streptococcus bacteria (there are a lot of them)
Group B Strep is a type of bacteria known as group B Streptococcus (GBS). It’s often found in the vagina and rectum of healthy women. GBS infection can occur in the urinary tract, reproductive organs, or in the blood. Although GBS is usually harmless in adults, it can cause serious illness in babies who get infected during birth. GBS infection can lead to meningitis, a serious infection of the brain and spinal cord. Pregnant women who develop GBS may be treated with antibiotics during labor to prevent their babies from getting sick.
What is a group B Strep test?
It is a swab that is done around 36 weeks. Then, it is sent to a lab that tests it for the presence of this bacteria.
BTW, many people think this is the same bacteria that causes Strep throat, but that is not the case. Strep throat is caused by Strep A — and obviously you swab your THROAT vs your lady parts….
What happens during a group B Strep test?
Most often your doctor will have you undress from the waist down and put your feet in the stirrups and then will swab the outer area of your vagina and then around your rectum. The GBS bacteria that is problematic is normally found in the secretions from your rectum and your vagina.
Sometimes they will offer a vaginal exam to check your cervix after this, although it is not normally needed a month out from your due date (although some pregnant people are curious and want to know).
However, I have heard of some doctors or midwives just handing the swab to the patient, asking them to go to the restroom and do it themselves. If you don’t feel comfortable doing it that way, you can ask them to do it, but it really is not a complicated test and you may feel more comfortable doing it that way.
When should I do a group B Strep test?
Routine Group B Streptococcus screen is done at around 36 weeks of pregnancy, although sometimes doctors will test your urine for it earlier, and if it comes back positive they will just treat you in labor.
Because it is done as a culture (vs a rapid Strep test like they might do for Strep throat), you will probably get the test result at your next appointment. The results are put in your chart and are sent to labor and delivery to note when you go into labor.
I also recommend pregnant women take note of specific health tests they have during labor to have for their own, and I talked about them in this podcast. It’s a great way to be the driver in your own healthcare.
I actually have a spot for all these important labs in my pregnancy planner.
Pro Tip: GBS can also cause urinary tract infections — so, some doctors routinely check for it in your urine to rule out a UTI early in your pregnancy.
What causes GBS in pregnancy?
It is a bacteria that lives on the skin of many of the adult population without any issue.
While some people call it a group B Strep infection — that means that you just have the bacteria in that area, not that it is actually problematic. It’s better to say it’s colonized (because it’s not a problem).
How common is GBS in pregnancy?
About 1 in 4 pregnant women test positive for GBS. So, pretty common.
Is Group Beta Strep an STI?
No, Group B Strep is not sexually-transmitted.
GBS can be transmitted by any surface, and the bacteria may come and go in your skin and body. We call this part of your “natural flora” that just lives on your skin. It is really important that both you and your partner realize this isn’t a BAD bacteria, it’s a normal bacteria that lives on the skin of many people (along with a bunch of other bacteria). It is not sexually transmitted, it’s just there.
Unless you are having a baby within the next month it isn’t problematic, unlike normal STI’s (which can cause many other health issues). And, your partner will NOT need to have antibiotic treatment as it is not normally a problem for normal, healthy adults.
Honestly, prenatal care can be really confusing for partners — so I created The Online Prenatal Class for Couples to explain a lot of it to both of you. People love it.
Is it possible to go into labor without being tested for group B Strep?
Yes, it happens frequently. The doctor will take into account a number of risk factors and may treat you “just in case” during labor. You’d be considered GBS unknown after birth and they would take similar precautions with the baby as they would if you were positive (it’s just more vital signs, etc — we’ll talk about it more below).
There are specific risk factors that would make you more at risk for GBS issues:
- If you were found GBS positive with a previous pregnancy
- If your amniotic sac (bag of waters) breaks before 37 weeks
- If your water is broken 18 hours or longer during labor
- If you have a fever during labor
If you have those things they will likely ask you if you want to be treated with antibiotics
If I am have a C-section Does GBS Matter?
Most often they will still culture you. If you were to have your water break before the cesarean section (meaning before you go back to the operating room, as the water will be broken before baby is born either way) they might treat you.
However if it is a scheduled C-section without any labor or rupture of membranes they normally don’t treat them.
The main issue is the baby coming through he vagina, or if the bacteria is able to populate inside the uterus and within the amniotic fluid when you are in labor.
Because beta strep can be problematic if it colonizes in your uterus, beta strep moms are at high risk for Chorioamnionitis or an infection of the amniotic sac and amniotic fluid. It can also cause an infection of the womb. Although these are pretty rare, and the main issue tends to be with the baby.
Are there any risks of being tested for GBS during pregnancy?
The main risk factor is finding out that you have it and being offered antibiotics during pregnancy if they are having a vaginal delivery.
For some reason many people are against having the antibiotics when they are in labor. We’ll talk more about why they offer them later in this post.
How did they figure-out GBS is a problem?
In the 1970’s many babies were getting an infection right after birth (within 6 days) — when they cultured mom’s, they found-out it happened to babies born to GBS positive moms.
They spent almost 20 years trying to figure how to decide which moms to treat.
It was in 1996 the American College of Obstetricians and Gynecologists, the American Academy of Pediatrics, and the Centers for Disease Control and Prevention came-up with guidelines to culture moms between 35 and 37 weeks of pregnancy and to recommend IV antibiotics to moms who came-up positive.
In following these guidelines there has been a huge decrease in the incidence of early-onset GBS disease.
Symptoms of Beta Strep in Pregnant Mothers
Most often the women who have GBS bacteria in their vaginal or rectal secretions are asymptomatic, unless they get a bladder infection from the bacteria.
How do they treat GBS positive moms?
Heads up! 👀 There may be affiliate links in here – I might earn a smidge with your click. No cost to you, just good vibes! Check my boring stuff for deets.
You’ll be given antibiotics once you are in active labor.
The gold standard treatment for GBS is penicillin (most often Pen-G) given IV, starting out with a larger dose and then a smaller dose every 4 hours until delivery. They aim to get antibiotics in you at least 4 hours before delivery (although some moms get several doses).
If you are allergic to penicillin they will opt for different antibiotic.
That basically very quickly wipes out all the bacteria in your vaginal area to let baby exit without an issue.
Your bacteria then repopulates quickly thereafter as you are not given antibiotics after baby is born (unless you have another issue). I do always recommend moms take a probiotic or eat yogurt or other good bacterial foods after taking these antibiotics, just to make sure you get those good bacteria back.
Can they just treat me with antibiotic pills for GBS?
They need to treat you with the high dose antibiotics right before delivery to wipe out the vaginal flora (the bacteria in your vagina) as baby passes through it.
Gecause you need the antibiotics before delivery is hard to tell when you should be taking them. And if you started oral antibiotics after you were in labor it wouldn’t be as effective as the IV kind (since they’re in your blood stream they are more effective and eliminated quicker from your system).
If you were to take the IV antibiotics a few days before delivery, the bacteria would just come back. So, IV antibiotics in active labor are your best bet.
Some women are treated for GBS in the urine earlier in pregnancy but that is due to a bladder infection, not for it being a problem for baby.
How do I get rid of GBS during pregnancy?
I have seen some people talking about douches or other things you can do either not be GBS positive before your culture or before delivery.
I know that some moms want to avoid having an IV in labor, but you can just have a saline lock and just have the antibiotics run every 4 hours through that.
However, there was a lot of testing that decided this was the safest route with the smallest amount of antibiotics as possible.
How can Group B Strep harm my baby?
Babies who are born vaginally to mothers who have GBS can develop severe infections that they can die from.
GBS is the most common cause of infection for newborns. Those who have it sometimes the present with pneumonia, meningitis or sepsis (an infection in your bloodstream).
Most often babies have symptoms within 24 hours after birth, but it can show up a week or more after birth (this is called late-onset GBS). It would be extremely rare to see any issues if baby is over 3 months old.
Will my baby be monitored for GBS after they are born?
Most hospitals have a policy for GBS positive babies. They often get more frequent vital sign checks (check heart, lungs, oxygenation and temperature).
If you don’t get the antibiotics, or if your baby has further risk factors, or shows signs of a problem, they may run a blood culture to check for the bacteria in the baby’s blood. This does require a blood draw.
It is just part of what they are watching for with your baby. If any issues are noted, your baby will go to the NICU to be monitored and possibly further testing.
Can I still breastfeed if my baby has a GBS infection?
Yes. Since it lives in your vagina/rectum it is fine to breastfeed if you are GBS positive.
That being said, some people choose to encapsulate their placentas. If you were GBS positive that can live in the dehydrated placenta and could then be passed to the baby via breastfeeding (same issues as deli meat during pregnancy and listeria — the placenta isn’t actually cooked to eliminate the bacteria).
For that reason they don’t recommend placental encapsulation in GBS positive moms. They also recommend if you’re having your placenta encapsulated to make sure the person doing it has a thorough cleaning process so that GBS can’t be passed to the next placenta. Learn more about that from the CDC here.
Should I be Worried if I am GBS positive?
It is normal to worry if baby will become sick from it. Honestly, the chance of infection from GBS is very low, and if you take proper treatments in labor you should be fine.
In fact, they don’t even test for GBS in the UK because the risk is so low (more on that in the next section).
Remember that worrying isn’t helping the issue and it could be hurting it. Do some positive affirmations!
Why don’t they test for GBS in the UK?
It looks like because the incidence rate is so low, they don’t test for it. They feel like the tests aren’t accurate enough, and often babies who have an issue with it are born prior to the time they would be screened.
Because this bacteria can come and go there is a chance you would be negative when they test, and positive at delivery. Or, bacteria is no longer on your skin at delivery but you still get antibiotics. It looks like they were going to test to see if it helped in 2020, but with Covid the testing was put aside for the other strains on healthcare.
If you are pregnant or thinking about becoming pregnant, it is important to be as informed as possible about all of the available screenings and tests. And it is extra important to discuss those issues with your provider — and not watch people on social media share things that may or may not be true.
GBS screening is a simple and relatively low-risk test that could potentially save your baby’s life. While there are some risks associated with taking the test, they are very small compared to the risks of not being screened for GBS. If you have any questions about GBS or other prenatal screenings, please talk to your doctor or midwife.
And, take a prenatal class. It will help you prepare for your birth and feel so much more confident about your delivery! The Online Prenatal Class for Couples takes less time than it takes to eradicate your vagina of GBS, so it’s pretty great!
And, if you’re not quite sure you’re ready for that whole thing, check out my free prenatal class. It’s your first step toward getting in the driver’s seat of your birth.

How Can You Increase Oxytocin to Induce Labor? The natural ways to induce labor

[…] weeks you normally have your GBS culture done at your prenatal appointments (I have a whole post on Group Beta Strep Screening). At this time, since you were already in the stirrups many providers checked cervixes at that […]